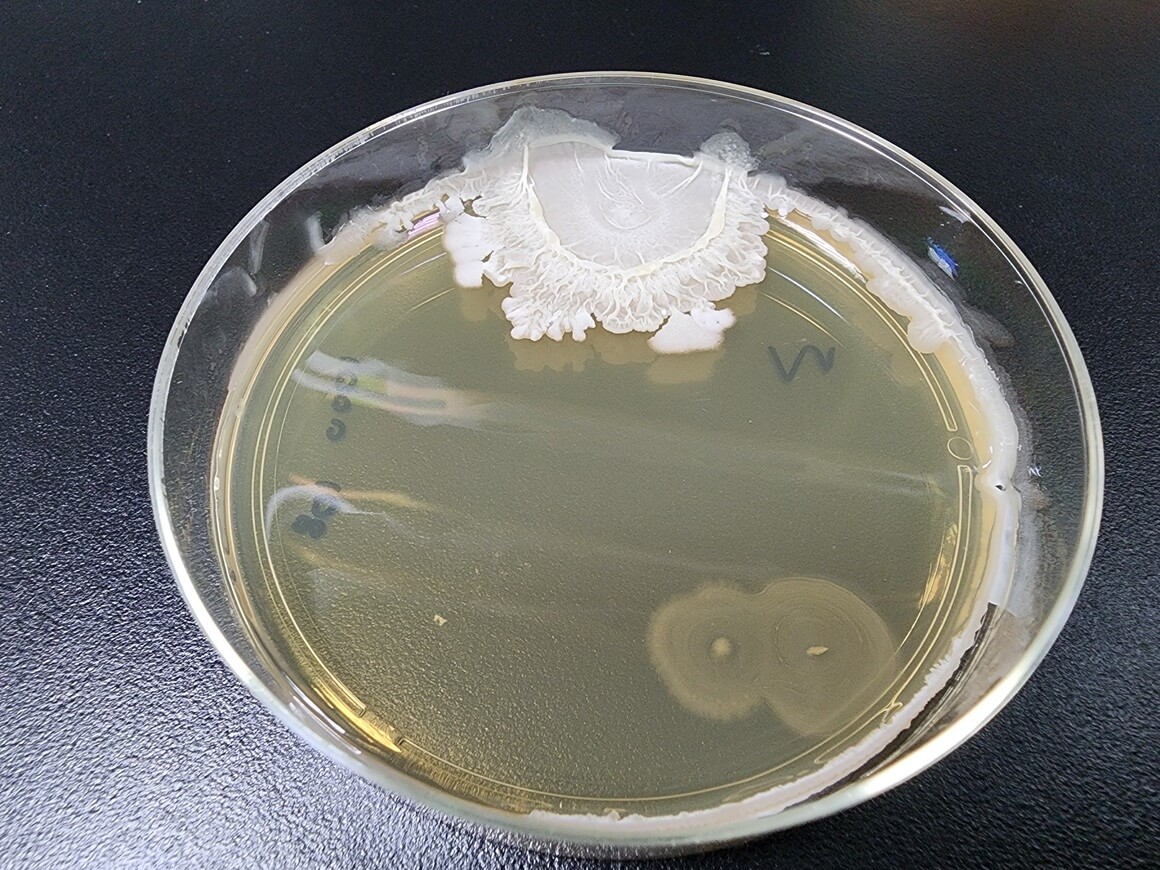
Bacillus cereus bakterija uzrokuje trovanje hranom

Bacillus cereus bakterija: Preživljava grijanje i uzrokuje trovanje! Evo gdje se nalazi
- Budite prvi i komentirajte!
- 3 min čitanja
Bacillus cereus bakterija je vrsta bakterije koja proizvodi toksine i može uzrokovati različite zdravstvene tegobe – od blažeg trovanja hranom do ozbiljnih, pa čak i životno ugrožavajućih infekcija.
Riječ je o bakteriji koja je široko rasprostranjena u okolišu, a najčešće se povezuje s nepravilnim čuvanjem i rukovanjem hranom.
Iako se većina ljudi s blažim oblikom infekcije oporavi unutar 24 sata, Bacillus cereus bakterija može predstavljati veći rizik za osobe oslabljenog imuniteta, novorođenčad i hospitalizirane pacijente.
Koliko je česta Bacillus cereus bakterija?
Infekcije koje uzrokuje Bacillus cereus bakterija prilično su česte, osobito kada je riječ o crijevnom obliku povezanom s trovanjem hranom.
Vrste infekcija koje uzrokuje Bacillus cereus bakterija
Postoje dvije vrste infekcije.
Necrijevni oblici Bacillus cereus bakterije
Necrijevni oblik ne zahvaća probavni sustav, već druge dijelove tijela. Bakterija se može pronaći u tlu, prašini, vodi i na biljkama, a u organizam ulazi kroz rane, dišne puteve ili medicinske instrumente.
Najčešće zahvaća:
- dišni sustav
- kožu i kirurške rane
- oči
- krvotok.
U težim slučajevima može uzrokovati meningitis, upalu pluća, infekcije srca, kostiju ili čak apscese mozga. Posebno opasna komplikacija je teška infekcija oka koja može dovesti do gubitka vida.
Crijevni oblici Bacillus cereus bakterije
Crijevni oblik najčešće se očituje kao trovanje hranom i obično prolazi samostalno. Ipak, kod osoba s oslabljenim imunitetom simptomi mogu biti izraženiji.

Dvije vrste crijevnih infekcija
Postoje dvije vrste crijevnih infekcija.
1. Dijarejski sindrom (enterotoksini)
Ovaj oblik je češći u Europi i SAD-u. Nakon konzumacije kontaminirane hrane, toksini se stvaraju u tankom crijevu. Simptomi se javljaju 6 – 15 sati nakon obroka.
Najčešći izvori su:
- meso i riba
- mliječni proizvodi
- juhe, umaci i variva
- povrće.
2. Povraćajući sindrom (emetički oblik)
Kod ovog oblika toksin je već prisutan u hrani prije konzumacije. Simptomi se javljaju vrlo brzo – unutar 1 – 6 sati.
Najčešći uzrok je kuhana riža koja je predugo stajala na sobnoj temperaturi, ali i:
- tjestenina
- peciva
- krumpir
- sushi
- sir.
Zašto Bacillus cereus bakterija uzrokuje trovanje hranom?
Bacillus cereus bakterija stvara spore koje mogu preživjeti visoke temperature. Ako se kuhana hrana ostavi na sobnoj temperaturi, spore se razmnožavaju i proizvode toksine. Čak i ponovno zagrijavanje hrane često nije dovoljno da ukloni toksine, zbog čega dolazi do trovanja.
Tko je u povećanom riziku?
Iako se svatko može zaraziti, veći rizik imaju:
- osobe s oslabljenim imunitetom
- osobe s kateterima
- intravenski korisnici droga
- osobe s otvorenim ranama ili nakon operacije
- novorođenčad.
Simptomi infekcije
Kod trovanja hranom najčešći simptomi su:
Kod necrijevnih infekcija simptomi ovise o zahvaćenom organu, a mogu uključivati:
- povišenu temperaturu
- umor
- bol i crvenilo oka
- smanjen vid.
Kako se postavlja dijagnoza?
Liječnik će najprije uzeti anamnezu, posebno podatke o nedavnom obroku. Za potvrdu se mogu analizirati uzorci hrane, stolice, povraćanog sadržaja ili krvi. Kod težih infekcija rade se dodatne laboratorijske i mikrobiološke pretrage.
Liječenje Bacillus cereus bakterije
Blago trovanje hranom najčešće prolazi samo od sebe uz mirovanje i dovoljan unos tekućine. U težim slučajevima potrebna je nadoknada tekućine infuzijom.
Necrijevne infekcije liječe se antibioticima, no važno je naglasiti da Bacillus cereus bakterija ponekad pokazuje otpornost na određene antibiotike. Liječenje se zato prilagođava svakom pacijentu pojedinačno.
Kako smanjiti rizik od zaraze?
Za prevenciju je ključno pravilno rukovanje hranom:
- čuvajte hladnu hranu ispod 5 °C
- toplu hranu držite iznad 60 °C
- ohlađenu hranu brzo spremite u hladnjak
- bacite hranu koja je dugo stajala na sobnoj temperaturi.
Redovito pranje ruku, pravilna njega rana i izbjegavanje rizičnih navika dodatno smanjuju rizik od necrijevnih infekcija.
Bacillus cereus bakterija i Bacillus subtilis bakterija – u čemu je razlika?
Iako pripadaju istoj skupini, Bacillus subtilis bakterija uglavnom se smatra bezopasnom i često se koristi u probioticima i znanstvenim istraživanjima, dok Bacillus cereus bakterija ima značajno veći patogeni potencijal i može izazvati ozbiljne zdravstvene probleme.
Pročitajte i ove članke:
- Trovanje hranom: Kada je opasno i kako si pomoći?
- Oprez! Ovo je 10 najrizičnijih namirnica za trovanje hranom!
- Jedete i tipkate po telefonu? To baš i nije najpametnija ideja.
Tekst Dana
Za vas izdvajamo
Sirup od lovora protiv kašlja: Prirodni recept koji smiruje suhi kašalj već nakon prve žličice
-
Kreni Zdravo
- 3 min čitanja
- Benisek, A. (2023). What Is Bacillus cereus? WebMD.
- Bacillus Cereus. (2022). Cleveland Clinic.